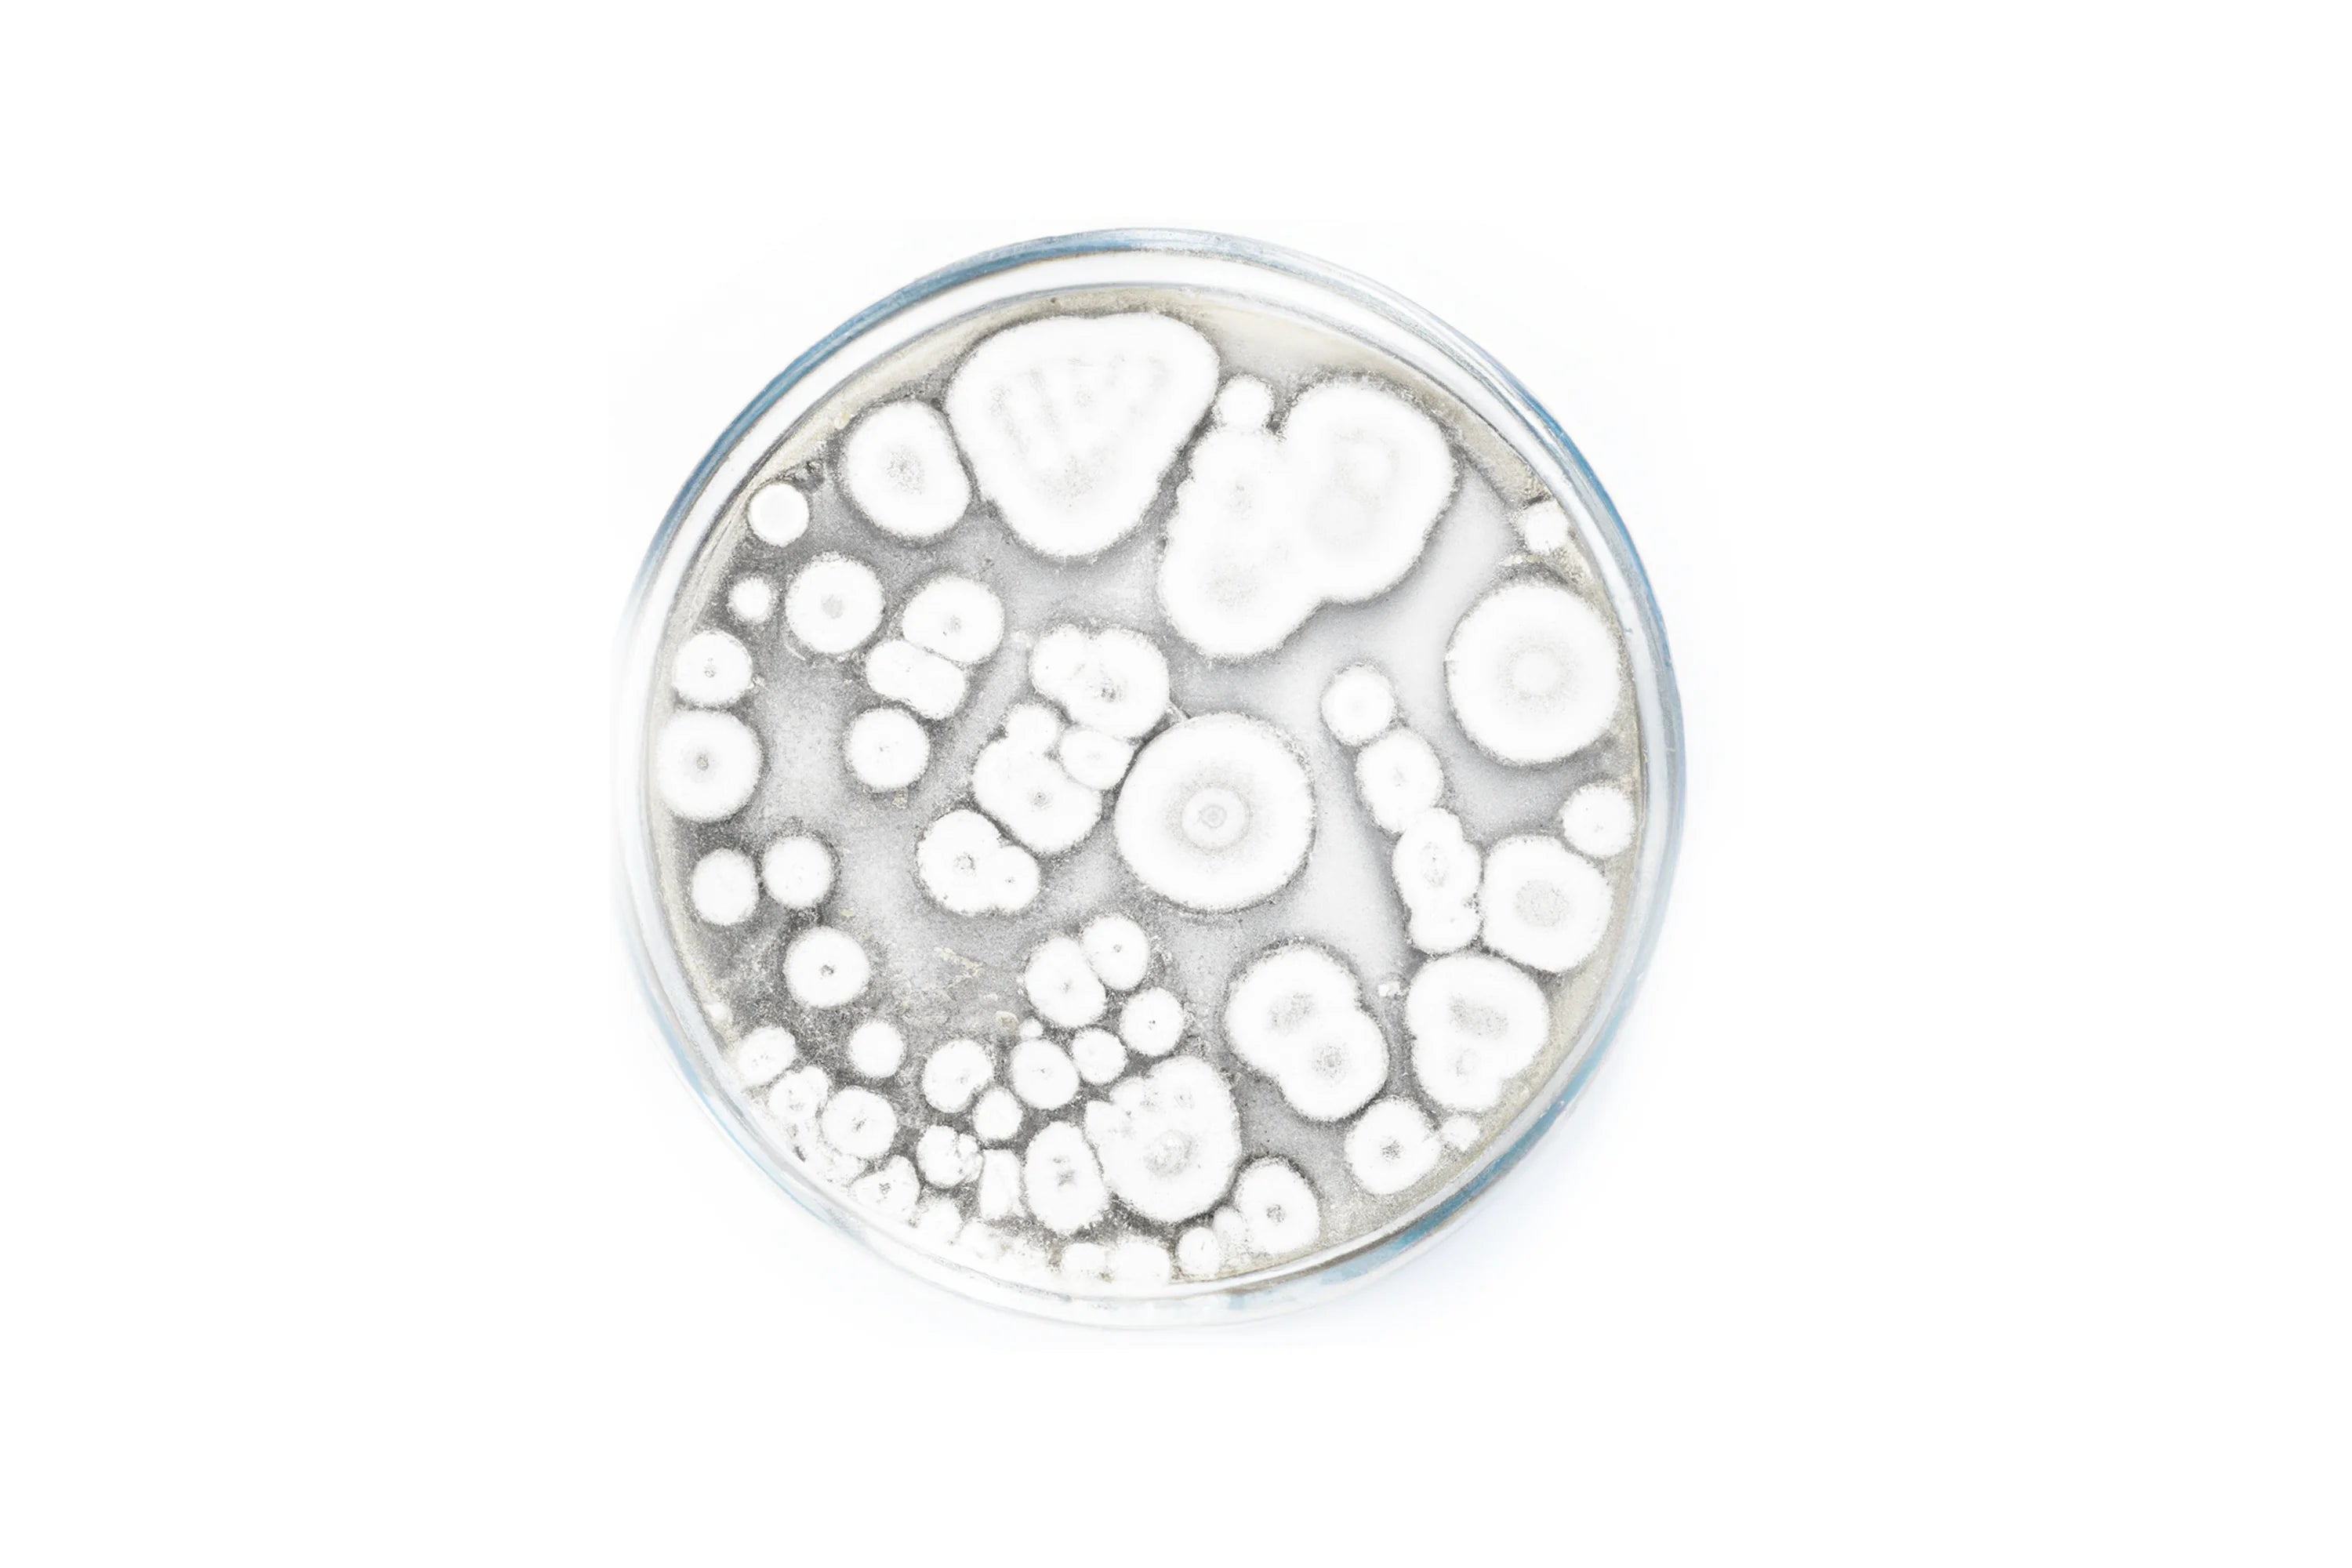

Ultimate Probiotic - Probiotic for Healthy Digestion & Digestive Tract
Ultimate Probiotic - Probiotic for Healthy Digestion & Digestive Tract
The Daily, Full-Spectrum Probiotic
Ultimate Probiotic combines 24 probiotic strains, 12 soil-based microorganisms, and a prebiotic blend with 100 billion CFUs per serving to support overall digestive health and well-being. Designed to help maintain a healthy balance of good bacteria in your gut, this supplement works to support digestion, nutrient absorption, and general immune health. A great addition to your daily wellness routine, Ultimate Probiotic helps ensure your digestive system stays balanced and supported.
See Full Ingredient List
Anyone who needs to balance their digestive system.
Take 2 capsules daily, 20 minutes before your first meal, with purified water or as recommended by your healthcare provider.
Awaiting stock
Estimated Delivery Times
✓ Cape Town: 1-2 Working Days
✓ Main Centres: 2-3 Working Days
✓ Regional Areas: 3 - 5 working days
✓ Remote Areas: 5-7 working days
Couldn't load pickup availability


UNIQUELY MADE
100 Billion CFUs. Maximum Potency.
Experience the gold standard in gut health with Global Healing's Ultimate Probiotic supplement. While other brands use low-quality strains and inflated CFU counts, we believe in quality over quantity. That's why we use only the highest quality strains in our vegan-friendly formula, expertly crafted to deliver maximum potency and effectiveness. With a concentrated 100 billion CFUs per bottle, our supplement ensures you get the full spectrum of gut-healing benefits from our probiotic strains with every dose.


THE BENEFITS
How Ultimate Probiotic Leads to a Better You.
Over 70% of your body’s immune system is in your gastrointestinal tract. A balanced gut strengthens your immune system, which helps your body defend itself from harmful organisms and seasonal distress.
Getting the most out of your meals comes down to the health of your gut bacteria. Don't miss out on essential nutrients by neglecting your probiotics. Ultimate Probiotic is here to help you optimize your digestion and absorb all the nutritional value your food offers. Probiotics relieve common digestive issues like gas, bloating, and constipation.
Ultimate Probiotic is the simple way to ensure your gut stays repopulated with healthy probiotics and prebiotics.
MADE WITH
Clean, Pure, Premium Ingredients

Prebiotics are non-digestible fibers that support the growth and activity of beneficial bacteria in the gut. Plus, prebiotics can help to improve immune function, reduce inflammation, and enhance nutrient absorption, among other benefits.
This formula contains 12 soil-based probiotics. Spore-based probiotics are highly stable and potent and have been shown to offer broad-spectrum benefits, meaning they can support the gut microbiome and immune system in multiple ways.

This formula contains 24 broad-spectrum, shelf-stable probiotic strains. These strains benefit from gut health and well-being, including improved digestive function, enhanced immune system support, and better nutrient absorption.

Frequently Asked Questions
For some people, probiotics can cause occasional gassiness and bloating, which typically subsides within a couple of weeks of regular use. If you experience this, start with half of a serving and increase as your body adjusts.
We generally recommend taking the capsules 20 minutes away from food to ensure maximum absorption. In your case, you can open the capsules and mix the powder, preferably in water or juice vs a smoothie.
Our ingredients are globally sourced depending on season and availability, and our products are made in our own manufacturing facility in Arizona. Rest assured that we also third-party test our ingredients for purity and potency. Here you have our commitment to quality and purity:https://globalhealing.com/pages/quality-purity
It's ideal for taking only two capsules once daily. At your discretion, you can also consume more capsules if needed or as recommended by your healthcare provider.
Having a strong microbiota is one of your best defenses against yeast, fungus, and other harmful organisms. So, depending on the individual, Ultimate Probiotic may assist with candida overgrowth. You can also check out the following Candida Support Bundle:https://globalhealing.com/products/candida-support-bundle
Due to the potency of its ingredients, Ultimate Probiotic is primarily intended for adults 18 years and up. While younger individuals have safely taken this product at about half of the suggested use, it's still essential to check with your children's natural healthcare provider before use to discuss a suitable serving size and protocol to meet their individual needs.
Generally, probiotics are safe to take during pregnancy. However, please also consult your healthcare provider before taking it if pregnant or breastfeeding.
Latero-Flora only contains the unique Brevibacillus laterosporus (BOD strain), which helps eliminate harmful organisms, balance candida overgrowth, and establish healthy intestinal flora colonies.
Ultimate Probiotic is a broad-spectrum, shelf-stable blend of 24 probiotic strains, 12 soil-based microorganism strains, and an advanced prebiotic blend known to promote optimal digestive health, immunity, and mood.
Ultimate Probiotic is shelf stable and does not require refrigeration.
Your digestive system already contains good bacteria — aka probiotics. The body needs these organisms for digestion, immune support, and mental health. While the digestive system is working hard to keep our guts running smoothly, it can also be disrupted on a daily basis by the foods we eat and even our environments. This is why it's important to repopulate your gut daily with a probiotic.